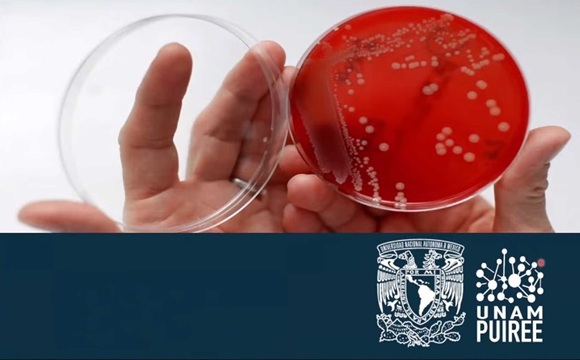

bacterias
-
Ciencia y Tecnología

Llaman a prevenir EPOC
El Hospital Civil de Guadalajara (HCG) llamó a la población a sumarse a la prevención de la enfermedad pulmonar obstructiva crónica (EPOC) y a la concientización sobre la resistencia antimicrobiana. El doctor Antonio Gerardo Rojas Sánchez, Jefe del Servicio de Fisiología Pulmonar e Inhaloterapia del Hospital Civil de Guadalajara “Fray Antonio Alcalde”, explicó que se busca la atención y la…
Leer más -
Ciencia y Tecnología
10 millones de personas podrían morir cada año por infecciones resistentes a los antibióticos
Para evitar que la resistencia microbiana siga creciendo es necesario reducir el uso, consumo y utilización de antibióticos, sostuvo el coordinador del Programa Universitario de Investigación sobre Riesgos Epidemiológicos y Emergentes de la UNAM, Samuel Ponce de León Rosales. Se calcula que a partir de 2050 podrían morir 10 millones de personas cada año por infecciones resistentes a los antibióticos,…
Leer más -
Ciencia y Tecnología

Estudian bacterias para descontaminar mar de hidrocarburos y plásticos
Bacterias del fondo marino del Golfo de México podrían emplearse para degradar hidrocarburos y plásticos que contaminan mares y playas, razón por la cual la investigadora del Instituto de Biotecnología (IBt) de esta casa de estudios, Liliana Pardo López, y su equipo de trabajo, estudian esos organismos. Numerosos plásticos están elaborados con materia prima de hidrocarburos, dijo en entrevista la…
Leer más -
Ciencia y Tecnología

Desarrolla IPN agrobiológico para combatir hongos en cultivo de maíz
Para detener el deterioro en raíz, tallo y mazorca de maíz, causado por el hongo Fusarium verticillioides, el cual afecta al país y provoca pérdidas en cosechas del estado de Sinaloa, investigadores del Instituto Politécnico Nacional (IPN) desarrollaron un compuesto agrobiológico a base de bacterias. Al ser el cultivo de maíz particularmente importante para ese estado y para todo México,…
Leer más -
Ciencia y Tecnología

Aumentan enfermedades gastrointestinales por “alimentos llovidos”
Las enfermedades gastrointestinales suelen presentar un alza durante el verano debido al fenómeno conocido como ingesta de “alimentos llovidos”. La lluvia es un vehículo portador de las toxinas que viven en la atmósfera y en el suelo, ya que en muchos espacios no se tienen procesos de bioseguridad y hay un nivel muy alto de polución, los cuales se filtran…
Leer más -
Ciencia y Tecnología

Emplean estudiantes microorganismos en cultivo de hortalizas para lograr una producción más eficiente
Con el objetivo de obtener lechugas más resistentes a plagas y enfermedades, poniendo al servicio de los productores de la región, prácticas que mejoren la eficiencia de producción con un gasto mínimo de agua, estudiantes de la carrera de Ingeniería en Innovación Agrícola Sustentable del Instituto Tecnológico Superior de Huichapan, realizan un proyecto de cultivos hidropónicos con Tricoderma y Quitosano,…
Leer más -
Ciencia y Tecnología

Desarrollan nanopartículas con propiedades antibacterianas y de regulación del calor
El algodón es el cultivo no alimentario más importante en el mundo, entre los principales usos que se le da a su fibra está la producción de textiles (hilo y tela). Recientemente, esta planta también ha cobrado interés para el desarrollo de materiales capaces de regular el calor, proteger contra bacterias o la radiación ultravioleta, entre otras aplicaciones. De acuerdo…
Leer más -
Galería principal

Alerta Cofepris sobre contaminación en frutas importadas de EUA
La Comisión Federal para la Protección contra Riesgos Sanitarios (Cofepris) informó sobre la posible contaminación con la bacteria Listeria monocytogenes en melocotón, ciruela y nectarina de la marca HMC Farms, luego de que la empresa HMC Group Marketing, INC llevara a cabo su retiro de los mercados en Estados Unidos por la misma razón. Esta autoridad sanitaria emitió un aviso…
Leer más -
Ciencia y Tecnología

Encuentran presencia de heces en quesos y cremas artesanales
Con el objetivo de verificar las condiciones de higiene de los quesos y cremas artesanales que se venden en los tianguis de la Ciudad de México, un grupo de investigadores del Departamento de Biomedicina Molecular del Cinvestav, analizó la presencia de microrganismos fecales o patógenos, por unidad de masa, volumen y lote. Durante dos años se analizaron muestras de queso…
Leer más
